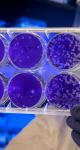

Entretien avec Michel Aglietta réalisé par Béatrice Couairon, Directrice du Programme Enseignants-Entreprises
Michel Aglietta est professeur émérite d'économie à l'Université Paris-Nanterre, conseiller scientifique au CEPII et membre honoraire de l'Institut universitaire de France.
Alors que l'économie réelle s'effondre sous l'impact du Covid-19, les marchés financiers chahutent voire rattrapent leur perte. Que faut-il y voir ?
Nous vivons plus que jamais en incertitude radicale. La finance n’a aucune capacité de structurer des anticipations pour l’avenir. Elle est sous l’emprise de son propre virus, le mimétisme suspendu aux annonces et décisions des banques centrales ; d’où les énormes fluctuations des marchés. Car les économies des pays prétendument « avancés » sont malades de l’endettement privé, pas de l’endettement public, qui s’est fortement aggravé depuis la grande financière de 2008. La double caractéristique du néolibéralisme, hyper concentration du capital et inégalités sociales extrêmes se traduisent au plan macro, surtout aux États-Unis, par une insuffisance de demande globale, une pression des lobbies sur les Etats dans la crise pandémique pour un sauvetage sans contrepartie, alors que ce sont les PMEs qui sont en grand danger. Le résultat selon les perspectives du FMI est l’incapacité de retrouver la trajectoire macro d’avant-crise avec un écart de PIB fin 2021 par rapport à la trajectoire d’avant crise pouvant aller de -2% à -10%. C’est dire l’ampleur de l’incertitude.
Comment l'Europe peut-elle retrouver une légitimité dans sa gestion de « l'après » et redonner du sens au projet commun ?
L’initiative toute récente et scandaleuse de la Cour constitutionnelle allemande prouve que l’on se trouve au pire de l’antagonisme Nord/Sud en Europe, qui empêche toute avancée de l’intégration et même toute coopération dans une situation de crise existentielle, non seulement pour l’Union, mais aussi pour chacun des pays membres. Il semble qu’il y ait incapacité de s’entendre sur un programme budgétaire commun et sur la stratégie d’investissement qu’il devrait prendre. Or deux erreurs majeures sont éviter. La première est de refaire avec les difficultés de l’Italie ce qui a été fait avec la Grèce en 2010 : austérité budgétaire généralisée qui a coûté à l’Europe 2 années de récession. Refaire cela avec un pays de la taille de l’Italie et dans le contexte beaucoup plus grave de la crise économique actuelle nous conduirait sans ambages à une dépression durable aussi grave que celle des années 1930.
La seconde erreur que les lobbies vont pousser est de revenir au monde d’avant, donc mettre de côté l’Accord de Paris sur le changement climatique et favoriser la poursuite de l’exacerbation des inégalités sociales dont ils tirent leur pouvoir. A contrario, il faut bien comprendre que la crise pandémique est la première des grandes crises environnementales de ce siècle. Elle est directement liée à la dégradation des écosystèmes et la perte de la biodiversité. Cela veut dire que l’investissement public massif pour entraîner le secteur privé dans la mise en œuvre immédiate de l’Accord de Paris est la seule solution à la sortie de crise, car il y a complémentarité forte entre une écologie politique pour la régénération de l’environnement et soutenabilité d’un régime de croissance sur la base d’un nouveau contrat social.
Quelles leçons pouvons-nous tirer de cette crise ?
L’essentiel est déjà contenu dans la fin de ma réponse précédente. La seule évolution possible pour ne pas mettre en grave péril le bien-être des générations futures est « Green New Deal ». La perspective ne peut advenir que si les élites politiques retrouvent le sens du long terme. Seule une mobilisation de la jeunesse dans le monde entier peut susciter la mutation des aspirations collectives pour un nouveau contrat social. De même qu’en 1945 le monde a commencé à changer parce que les élites politiques qui avaient permis l’engrenage fatal dans la Grande Dépression ont été discréditées, de même nous devons nous convaincre qu’un nouveau contrat social comprenant une solidarité multilatérale est l’enjeu de ce siècle.